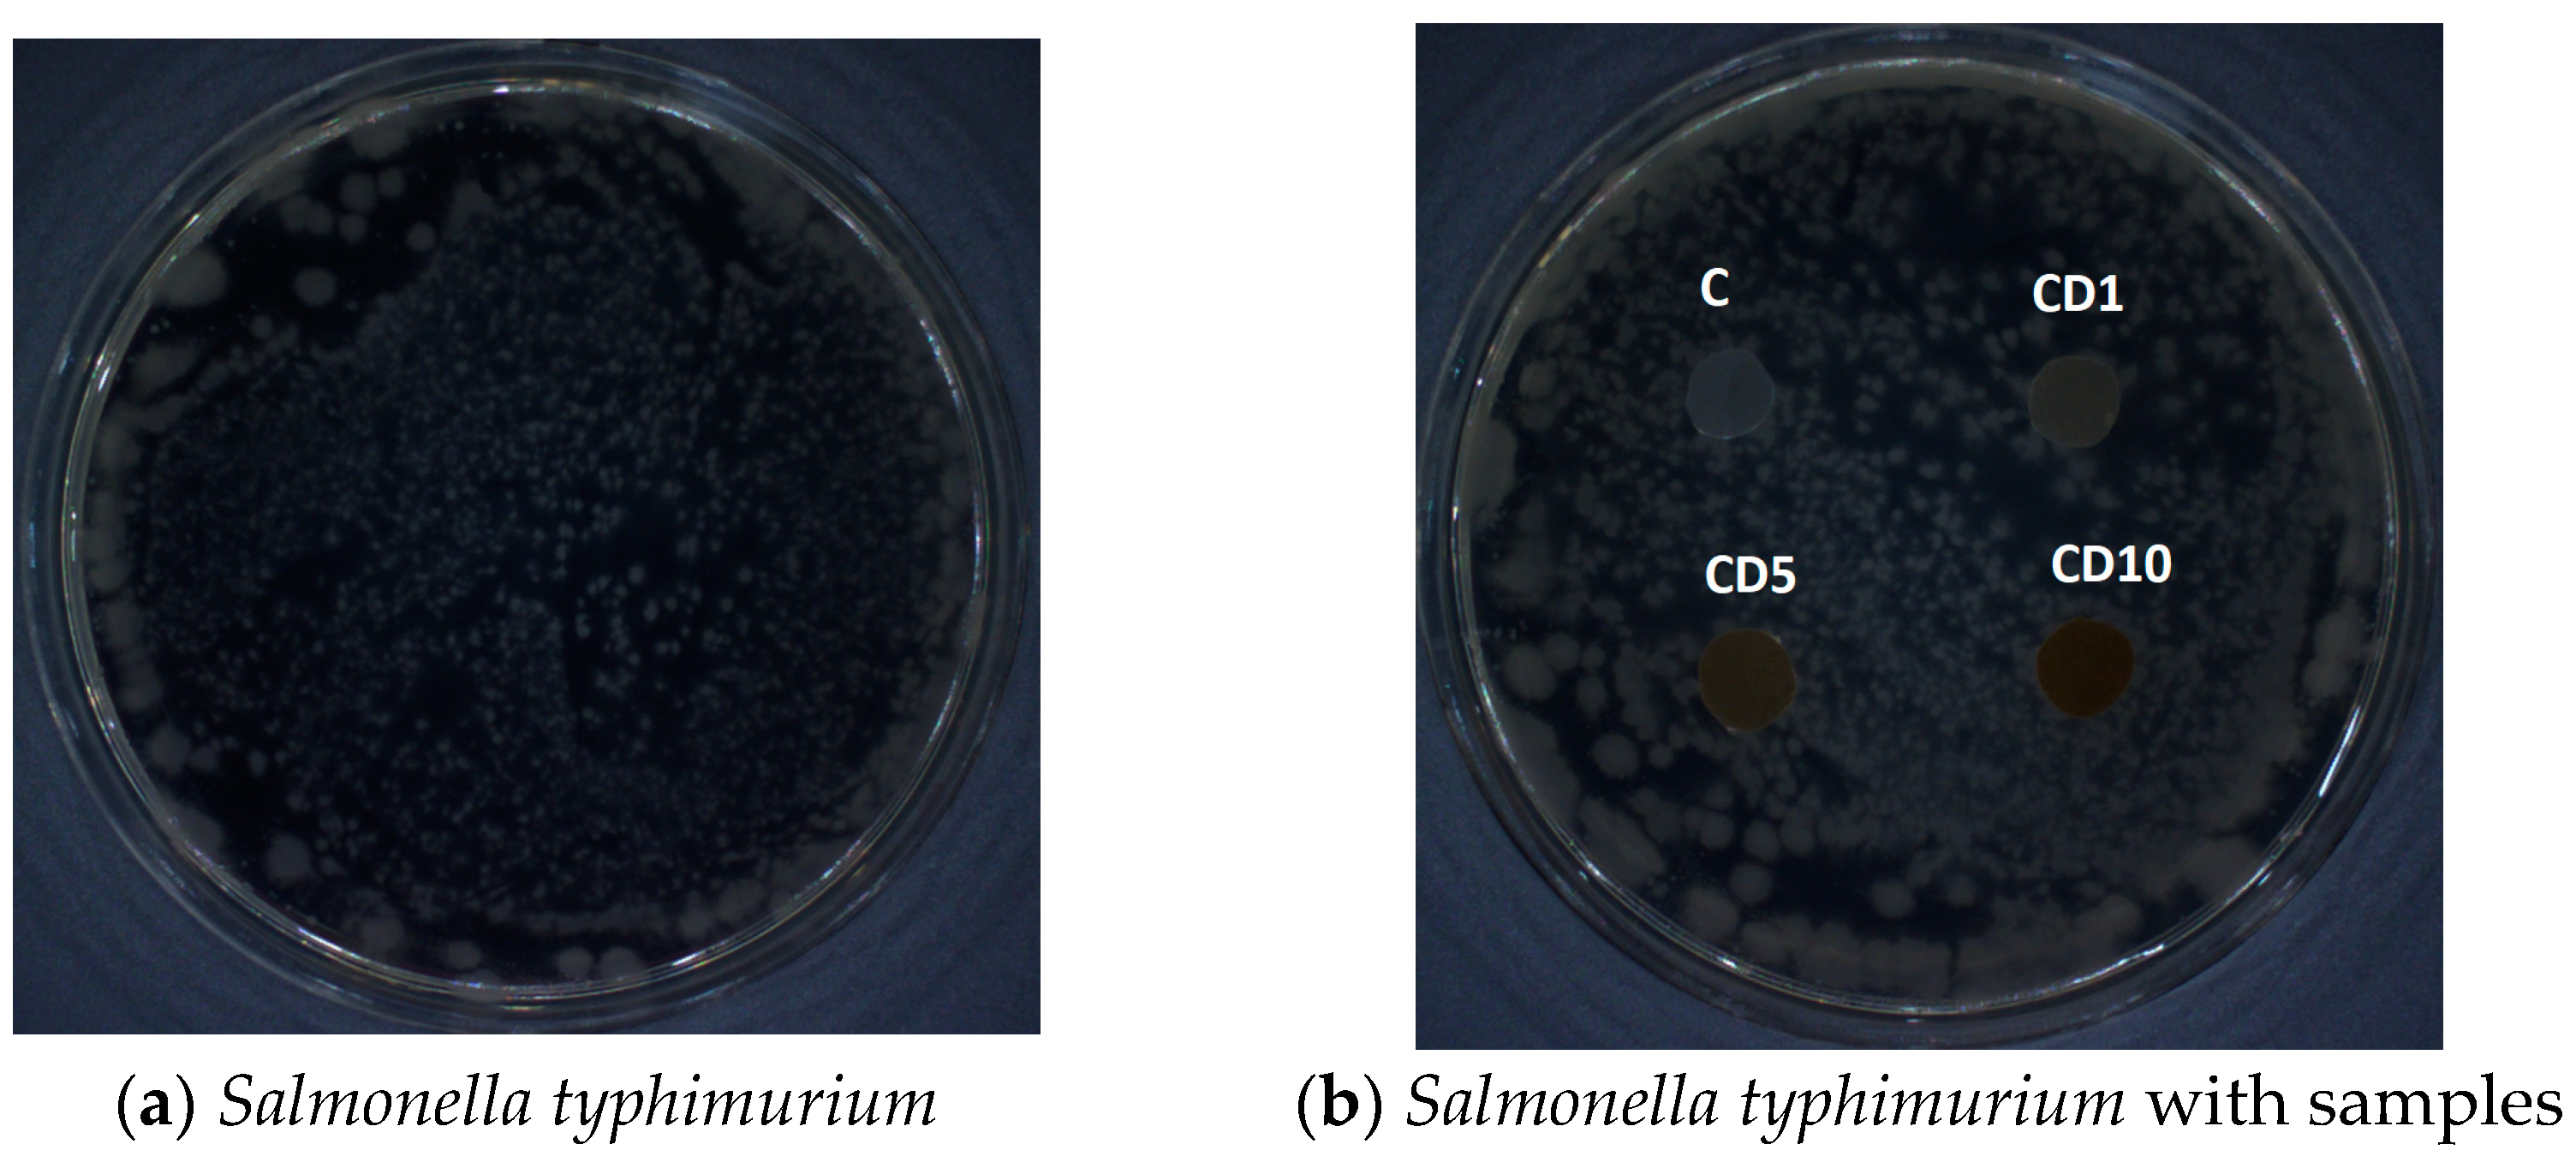
Foods 12 04244 g009

Polycaprolactone-Based Films Incorporated with Birch Tar—Thermal, Physicochemical, Antibacterial, and Biodegradable Properties
Abstract
1. Introduction
2. Materials and Methods
2.1. Materials
2.2. Polycaprolactone-Based Materials Formation
2.3. FTIR Analysis
2.4. Thermal Properties
2.5. Mechanical Properties
2.6. Color Analysis
2.7. Transparency
2.8. Permeability of Water and Oxygen Transmission Rate (OTR)
2.9. Antibacterial Effect
2.10. Ames Test
2.11. Biodegradability
3. Results and Discussion
3.1. Fourier Transform Infrared Spectroscopy
3.2. Thermogravimetric Analysis
3.3. Film Thickness
3.4. Changes in Mechanical Properties
3.5. Analysis of the Color and Transparency of the Film
3.6. Water Vapor Permeability and OTR
3.7. Antibacterial Properties
3.8. Ames Test—Mutagenicity Method
3.9. Biodegradability
4. Conclusions
Author Contributions
Funding
Data Availability Statement
Conflicts of Interest
References
- Malinowski, R.; Fiedurek, K.; Rytlewski, P.; Puszczykowska, N.; Kaczor, D.; Stasiek, A. The structure and selected properties of poly(ε-caprolactone)-based biodegradable composites with high calcium carbonate. Sci. Total. Environ. 2023, 867, 161528. [Google Scholar] [CrossRef]
- Richert, A.; Kalwasińska, A.; Jankiewicz, J.; Swiontek Brzezinska, M. Effect of birch tar embedded in polylactide on its biodegradation. Int. J. Biol. Macromol. 2023, 239, 124226. [Google Scholar] [CrossRef]
- Silva, D.F.; Lima, K.T.; Bastos, G.N.T.; Oliveira, J.A.R.; Nascimento, L.A.S.; Costa, C.E.F.; Filho, G.N.R.; Concha, V.O.C.; Passos, M.F. PCL/Andiroba Oil (Carapa guianensis Aubl.) Hybrid Film for Wound Healing Applications. Polymers 2021, 13, 1591. [Google Scholar] [CrossRef]
- Sun, T.; Shuai, X.; Ren, K.; Jiang, X.; Chen, Y.; Zhao, X.; Song, Q.; Hu, S.; Cai, Z. Amphiphilic Block Copolymer PCL-PEG-PCL as Stationary Phase for Capillary Gas Chromatographic Separations. Molecules 2019, 24, 3158. [Google Scholar] [CrossRef] [PubMed]
- Sogut, E.; Seydim, A.C. Development of Chitosan and Polycaprolactone based active bilayer films enhanced with nanocellulose and grape seed extract. Carbohydr. Polym. 2018, 195, 180–188. [Google Scholar] [CrossRef]
- Suzuki, Y.; Duran, H.; Akram, W.; Steinhart, M.; Floudas, G.; Butt, H. Multiple nucleation events and local dynamics of poly-(3-caprolactone) (PCL) confined to nanoporous alumina. Soft Matter. 2013, 9, 9189–9198. [Google Scholar] [CrossRef]
- Hagner, H.; Penttinen, O.P.; Pasanen, T.; Tiilikkala, K.; Setala, H. Acute toxicity of birch tar oil on aquatic organisms. Agric. Food Science 2010, 19, 24. [Google Scholar] [CrossRef]
- Hagner, M.; Pasanen, T.; Lindqvist, B.; Lindqvist, I.; Tiilikkala, K.; Penttinen, O.P.; Setala, H. Effects of birch tar oils on soil organisms and plants. Agric. Food Sci. 2010, 19, 13. [Google Scholar] [CrossRef]
- Lindqvist, I.; Lindqvist, B. Birch tar oil is an effective mollusc repellent: Field and laboratory experiments using Arianta arbustorum (Gastropoda: Helicidae) and Arion lusitanicus (Gastropoda: Arionidae). Agric. Food Sci. 2010, 19, 1. [Google Scholar] [CrossRef][Green Version]
- Richert, A.; Olewnik-Kruszkowska, E.; Dąbrowska, G.B.; Dąbrowski, H.P. The Role of Birch Tar in Changing the Physicochemical and Biocidal Properties of Polylactide-Based Films. Int. J. Mol. Sci. 2022, 23, 268. [Google Scholar] [CrossRef]
- Adfa, M.; Romayasa, A.; Kusnanda, A.J.; Avidlyandi, A.; Yudha, S.S.; Banon, C.; Gustian, I. Chemical Components. J. Korean Wood Sci. Technol. 2020, 48, 107. [Google Scholar] [CrossRef]
- Oramahi, H.; Yoshimura, T.; Rusmiyanto, E.; Kustiati, K. Antifungal and larvicidal effects of wood vinegar on wood-destroying fungi and insects. J. Appl. Biol. Sci. 2020, 14, 26. [Google Scholar]
- Akkuş, M.; Akçay, Ç.; Yalçın, M. Antifungal and larvicidal effects of wood vinegar on wood-destroying fungi and insects. Maderas-Cienc. Technol. 2022, 24, 5. [Google Scholar]
- Meade, E.; Savage, M.; Slattery, M.; Garvey, M. Investigation of Alternative Therapeutic and Biocidal Options to Combat Antifungal-Resistant Zoonotic Fungal Pathogens Isolated from Companion Animals. Infect. Dis. Rep. 2021, 13, 34. [Google Scholar] [CrossRef] [PubMed]
- Richert, A.; Kalwasinska, A.; Swiontek Brzezinska, M.; Dąbrowska, G. Biodegradability of Novel Polylactide and Polycaprolactone Materials with Bacteriostatic Properties Due to Embedded Birch Tar in Different Environments. Int. J. Mol. Sci. 2021, 22, 10228. [Google Scholar] [CrossRef]
- Birch tarr. Available online: https://en.wikipedia.org/wiki/Birch_tar (accessed on 14 November 2023).
- Blondeau, D.; St-Pierre, A.; Bourdeau, N.; Bley, J.; Lajeunesse, A.; Desgagné-Penix, I. Antimicrobial activity and chemical composition of white birch (Betula papyrifera Marshall) bark extracts. Microbiologyopen 2020, 9, e00944. [Google Scholar] [CrossRef]
- Richert, A.; Dąbrowska, G.B.; Dąbrowski, H.P. Bactericidal Polylactide Film and the Method of Its Preparation. Patent Application P.433979, 2020. (In Polish). [Google Scholar]
- Richert, A.; Dąbrowska, G.B. Method for Obtaining a Biodegradable Film from Biodegradable Polymers and a Biodegradable Film Containing Biodegradable Polymers. Patent Application P.442284, 2022. (In Polish). [Google Scholar]
- Richert, R.; Malinowski, M.; Ringwelska, G.B.; Dąbrowska, B.T. Introduced into polylactide and its influence on the barrier, thermal, functional and biological properties of the film obtained by industrial extrusion. Materials 2022, 15, 7382. [Google Scholar] [CrossRef]
- ISO 527-1:2020; Plastics—Determination of Tensile Properties—Part 1: General Principles. International Organization for Standardization: Geneva, Switzerland, 2020.
- ISO 527-3:2019; Plastics—Determination of Tensile Properties—Part 3: Test Conditions for Films and Sheets. International Organization for Standardization: Geneva, Switzerland, 2019.
- Jakubowska, E.; Gierszewska, M.; Nowaczyk, J.; Olewnik-Kruszkowska, E. The role of a deep eutectic solvent in changes of physicochemical and antioxidative properties of chitosan-based films. Carbohydr. Polym. 2021, 255, 117527. [Google Scholar] [CrossRef]
- ISO 22196:2011; Measurement of Antibacterial Activity on Plastics and Other Non-Porous Surfaces. International Organization for Standardization: Geneva, Switzerland, 2011.
- Swiontek Brzezinska, M.; Richert, A.; Kalwasińska, A.; Świątczak, J.; Deja-Sikora, E.; Walczak, M.; Michalska-Sionkowska, M.; Piekarska, K.; Kaczmarek-Szczepańska, B. Microbial degradation of polyhydroxybutarate with embedded polyhexamethyleneguanidine derivatives. Int. J. Biol. Macromol. 2021, 187, 309–318. [Google Scholar] [CrossRef]
- Platen, H.; Wirtz, A. The measurement of respiration activity soil with a respirometric method (measuring system Oxi TopControl). In WTW/OxiTopR/Appliance; Fachbereich, K.M.U.B., Ed.; Umwelt-und Hygienetechnik und Zentrum für Umwelttechnologie: Giessen, Germany, 1999. [Google Scholar]
- Coleman, M.M.; Zarian, J.J. Fourier-transform infrared studies of polymer blends. II. Poly (ϵ-caprolactone)–poly (vinyl chloride) system. Polym. Sci. Part-B 1979, 17, 837–850. [Google Scholar]
- Lyu, J.S.; Lee, J.S.; Han, J. Development of a biodegradable polycaprolactone film incorporated with an antimicrobial agent via an extrusion process. Sci. Rep. 2019, 9, 20236. [Google Scholar] [CrossRef] [PubMed]
- Khatiwala, V.K.; Shekhar, N.; Aggarwal, S.; Mandal, U.K. Biodegradation of Poly(ε-caprolactone) (PCL) Film by Alcaligenes faecalis. J. Polym. Environ. 2008, 16, 61–67. [Google Scholar] [CrossRef]
- Reshmi, C.R.; Suja, P.S.; Juraij, A.; Sujith, A. Fabrication of superhydrophobic polycaprolactone/beeswax electrospun membranes for high-efficiency oil/water separation. RSC Adv. 2017, 7, 2092. [Google Scholar]
- Lipiec, J.; Janas, P. Ćwiczenie 6. Właściwości Sprężyste Ciał Stałych; Zakład Fizyki, Uniwersytet Rolniczy: Krakow, Poland, 2016. [Google Scholar]
- Blicharski, M. Wstęp do Inżynierii Materiałowej; Wydawnictwa Naukowo-Techniczne: Warsaw, Poland, 2001; pp. 86–89. [Google Scholar]
- Ciechomski, W. Opakowanie jako instrument promocji. LogForum 2008, 4, 4. [Google Scholar]
- Wszołek, M.; Moszczyński, K.; Mackiewicz, P. Wpływ Barwy i Etykiety Opakowań na Postrzeganie Produktu—Wyniki Badań Empirycznych; Wydawnictwo LIBRON: Krakow, Poland, 2017; pp. 77–122. (In Polish) [Google Scholar]
- Pathare, P.B.; Opara, U.L.; Al-Said, F.A.-J. Colour measurement and analysis in fresh and processed foods: A review. Food Bioprocess Technol. 2013, 6, 36–60. [Google Scholar] [CrossRef]
- Pritchard, R. The transparency of crystalline polymers. Polym. Eng. Sci. 1964, 4, 66–71. [Google Scholar] [CrossRef]
- Galus, S.; Lenart, A. Wpływ powlekania na stabilność żywności. Postępy Tech. Przetwórstwa Spożywczego 2019, 2, 106–114. [Google Scholar]
- Fagernäs, L.; Eeva, K.; Kari, T.; Oasmaa, A. Chemical composition of birch wood slow pyrolysis products. Energy Fuel 2012, 26, 1275–1283. [Google Scholar] [CrossRef]
- Fujisawa, S.; Atsumi, T.; Kadoma, Y.; Sakagami, H. Antioxidant and prooxidant action of eugenol-related compounds and their cytotoxicity. Toxicology 2002, 177, 39–54. [Google Scholar] [CrossRef]
- Rathinam, P.; Vijay Kumar, H.S.; Viswanathan, P. Eugenol exhibits anti-virulence properties by competitively binding to quorum sensing receptors. Biofouling 2017, 33, 624–639. [Google Scholar] [CrossRef]
- Marchese, A.; Barbieri, R.; Coppo, E. Antimicrobial activity of eugenol and essential oils containing eugenol: A mechanistic viewpoint. Crit. Rev. Microbiol. 2017, 43, 668–689. [Google Scholar] [CrossRef] [PubMed]
- Yang, C.M.; Chathuranga, K.; Lee, J.S.; Park, W.H. Effects of polyphenols on the thermal decomposition, antioxidative, and antimicrobial properties of poly(vinyl alcohol) and poly(vinyl pyrrolidone). Polym. Test. 2022, 116, 107786. [Google Scholar] [CrossRef]
- Rana, A.; Samtiya, M.; Dhewa, T.; Mishra, V.; Aluko, R.E. Health benefits of polyphenols: A concise review. J. Food. Biochem. 2022, 46, e14264. [Google Scholar] [CrossRef] [PubMed]

| Description | Clear PCL [Lyu, Khatiwala] [cm−1] | Sample C [cm−1] |
|---|---|---|
| Symmetric and asymmetric stretching vibrations CH2 | 2943 2864 | 2918 2864 |
| Stretching vibrations C=O, carbonyl group | 1727 | 1726 |
| Stretching vibrations C-C | 1294 | 1249 1301 |
| Stretching vibrations C-O-C | 1167 | 1156 1158 1162 |
| Samples | C | CD1 | CD5 | CD10 |
|---|---|---|---|---|
| Thickness [mm] | 0.088 ± 0.008 | 0.082 ± 0.011 | 0.064 ± 0.010 | 0.077 ± 0.010 |
| Samples | L | a | b |
|---|---|---|---|
| C | 91.3 ± 0.1 | 1.0 ± 0.0 | −10.6 ± 0.3 |
| CD1 | 79.9 ± 1.1 | 2.2 ± 0.0 | 6.9 ± 1.1 |
| CD5 | 59.2 ± 1.8 | 6.7 ± 0.4 | 17.3 ± 0.5 |
| CD10 | 47.8 ± 0.2 | 9.0 ± 0.1 | 18.3 ± 0.3 |
| Sample Description | Sample Description | R | % Reduction | Antimicrobial Efficacy |
|---|---|---|---|---|
| X. campestris | C | - | - | - |
| CD1 | 2.2 | >99.9 | very good | |
| CD5 | 2.8 | >99.9 | very good | |
| CD10 | 3.2 | >99.9 | very good | |
| P. brassicacearum | C | - | - | - |
| CD1 | 1.9 | >90.0 | satisfactory | |
| CD5 | 2.1 | >99.9 | very good | |
| CD10 | 2.5 | >99.9 | very good | |
| P. corrugata | C | - | - | - |
| CD1 | 2.1 | >99.9 | very good | |
| CD5 | 2.4 | >99.9 | very good | |
| CD10 | 2.8 | >99.9 | very good | |
| P. syringae | C | - | - | - |
| CD1 | 1.9 | >90.0 | satisfactory | |
| CD5 | 2.0 | >99.9 | very good | |
| CD10 | 2.2 | >99.9 | very good | |
| E. coli (ATCC 8739P) | C | - | - | - |
| CD1 | 1.5 | >90.0 | satisfactory | |
| CD5 | 1.7 | >99.9 | satisfactory | |
| CD10 | 1.9 | >90.0 | very good | |
| S. aureus (ATCC 65388) | C | - | - | - |
| CD1 | 1.7 | >90.0 | satisfactory | |
| CD5 | 1.8 | >90.0 | satisfactory | |
| CD10 | 2.0 | >99.9 | very good | |
| P. aeruginosa (ATCC 8739) | C | - | - | - |
| CD1 | 2.0 | >99.9 | very good | |
| CD5 | 2.3 | >99.9 | very good | |
| CD10 | 2.5 | >99.9 | very good |
| Sample | BOD after 14 Days of Biodegradation in: | |||
|---|---|---|---|---|
| Water River | Soil | Compost | Water Lake | |
| C | 530 ± 0.12 d | 520 ± 0.26 b | 602 ± 0.15 b | 61 ± 0.33 c |
| CD1 | 25 ± 0.09 c | 252 ± 0.11 b | 216 ± 0.10 b | 28 ± 0.41 b |
| CD5 | 20 ± 0.23 d | 176 ± 0.05 c | 204 ± 0.21 a | 23 ± 0.20 a |
| CD10 | 3 ± 0.15 d | 160 ± 0.34 b | 96 ± 0.31 b | 8 ± 0.05 c |
Disclaimer/Publisher’s Note: The statements, opinions and data contained in all publications are solely those of the individual author(s) and contributor(s) and not of MDPI and/or the editor(s). MDPI and/or the editor(s) disclaim responsibility for any injury to people or property resulting from any ideas, methods, instructions or products referred to in the content. |
© 2023 by the authors. Licensee MDPI, Basel, Switzerland. This article is an open access article distributed under the terms and conditions of the Creative Commons Attribution (CC BY) license (https://creativecommons.org/licenses/by/4.0/).
Share and Cite
Richert, A.; Olewnik-Kruszkowska, E.; Malinowski, R.; Kalwasińska, A.; Swiontek Brzezinska, M. Polycaprolactone-Based Films Incorporated with Birch Tar—Thermal, Physicochemical, Antibacterial, and Biodegradable Properties. Foods 2023, 12, 4244. https://doi.org/10.3390/foods12234244
Richert A, Olewnik-Kruszkowska E, Malinowski R, Kalwasińska A, Swiontek Brzezinska M. Polycaprolactone-Based Films Incorporated with Birch Tar—Thermal, Physicochemical, Antibacterial, and Biodegradable Properties. Foods. 2023; 12(23):4244. https://doi.org/10.3390/foods12234244
Chicago/Turabian StyleRichert, Agnieszka, Ewa Olewnik-Kruszkowska, Rafał Malinowski, Agnieszka Kalwasińska, and Maria Swiontek Brzezinska. 2023. "Polycaprolactone-Based Films Incorporated with Birch Tar—Thermal, Physicochemical, Antibacterial, and Biodegradable Properties" Foods 12, no. 23: 4244. https://doi.org/10.3390/foods12234244
APA StyleRichert, A., Olewnik-Kruszkowska, E., Malinowski, R., Kalwasińska, A., & Swiontek Brzezinska, M. (2023). Polycaprolactone-Based Films Incorporated with Birch Tar—Thermal, Physicochemical, Antibacterial, and Biodegradable Properties. Foods, 12(23), 4244. https://doi.org/10.3390/foods12234244








